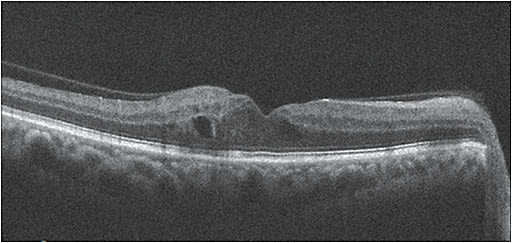
Note this patient’s DME, as seen on OCT.
Courtesy of Sherrol A. Reynolds, O.D., F.A.A.O.

AMERICAN DIABETES ASSOCIATION POSITION STATEMENT GUIDES PRACTITIONERS
I RECENTLY read an article in the Los Angeles Times that included the statement that diabetes is about as American as, “baseball, hot dogs and apple pie.” In looking at the CDC’s National Diabetes Statistics Report, 2017, I must agree.
Specifically, this sight-stealing condition affects more than 30.3 million, or one in 10, Americans, according to the report, with about 7.2 million adults unaware they have it, or undiagnosed. Another 84.1 million adults are pre-diabetic.
These numbers serve to sustain the impact of diabetic eye disease — diabetic retinopathy (DR) and its associated pathology, including diabetic macular edema (DME) — as the leading cause of severe vision loss and blindness in Americans of working age. In fact, the NEI projects DR to climb to 11 million by 2030. What’s more, some people who have significant sight-threatening retinopathy are often asymptomatic for their diabetes and, therefore, don’t know they have DR. And, frighteningly, a total of 60% of those who are aware of their condition are not getting annual dilated exams, according to BMJ Open Diabetes Research and Care 2017.
The good news: Diagnostic assessment and treatment options for DR have dramatically improved in recent years, so much so that the American Diabetes Association (ADA) recently published a position statement on DR — the first such update since 2002.
Here, I discuss the ADA statement’s recommendations for the diagnosis and management of DR, so we can intervene sooner vs. later and provide these patients a chance of retaining their vision.
Learning Points
- Optimize glycemic control (HbA1c ≤7), blood pressure (<140/90), and lipid to prevent or slow progression of DR.
- Testing should include retinal photography, SD-OCT, SD-OCTA, and ultra wide-field imaging.
- Treatment is anti-VEGF for center-involved DME and PDR
- Work with the patient’s entire health care team.
DIAGNOSIS
The statement recommends retinal photography to aid in the diagnosis of DR. Examples of this technology:
- Fundus photography. This aids in the detection of DR, as it exposes subtle changes, such as microaneurysms and macular thickening. The technology is valuable for documenting the severity of DR, response to treatment and patient education.
That said, while retinal photography may serve as a screening tool for retinopathy, it is not a substitute for a comprehensive eye exam, according to the ADA statement. - SD-OCT. This should be performed routinely on all patients who have diabetes, the ADA statement says. It aids in detecting DME, specifically center-involved DME. SD-OCT has become the standard to quantify retinal thickness, monitor DME and respond to treatment.
- OCT angiography. This emerging imaging modality helps in the identification of early retinal microvasculature changes, such as microaneurysms — the earliest sign of DR — and often not observed clinically.
Other microvascular changes that can be identified with the help of OCTA: capillary non-perfusion (i.e. enlarged foveal avascular zone), vascular anomalies, such as vascular loops, tortuosity and dilations of the vessels, intraretinal microvascular abnormalities and superficial neovascularization. - Ultra-Widefield imaging. This ocular technology enables the rapid visualization of the retinal periphery for signs of neovascularization or capillary ischemia, thus, facilitating the earlier diagnosis of DR.
MANAGEMENT
Regarding managing DR patients, the ADA statement emphasizes the importance of “good” diabetes control (glycemic control, blood pressure and lipid control) to reduce the risk or slow the progression of DR.
Specifically, “good” glycemic control is defined as HbA1c ≤7, as observed in major diabetes studies, such as the Diabetes Control and Complications Trial.
Regarding blood pressure, it should be less than 140/90, according to the Eighth Joint National Committee on Hypertension.
Further, the statement recommends the lipid-lowering medication fenofibrate, as its benefit was observed in the Fenofibrate Intervention and Event study. (Be aware that statins have been linked with hyperglycemia.)
We, as primary care providers, can use this data to provide patient education, monitor them and collaborate better with the treating physician.
Something else we can educate our diabetic patients on: the importance of dilated retinal examinations. Specifically, the ADA statement recommends all patients who have Type 1 diabetes undergo one within five years after the onset of diabetes; all Type 2 patients have one at the time of diagnosis; and pregnant women who have diabetes undergo a dilated retinal examination in the first trimester and, subsequently, every trimester after.
For patients who have diabetes, but no DR, the ADA statement recommends a two-year eye examination interval, though this should be tempered by the patient’s risk factors, such as glycemic control. (With the use of newer imaging technologies, such as OCTA, which aids in the detection of microaneurysms before they are clinically evident, this recommendation may change.)
Of interest: The ADA statement also says retinal telescreening may be effective to aid in the identification of DR when the ratio of providers to patients is low, the distance to reach a provider is prohibitive or the alternative is no patient screening.
The ADA statement recommends monthly anti-VEGF agents for central-involved DME (macular edema involving the center of the fovea of the macula), as serial injections of these agents reduce macular edema, preserving or improving vision for patients who have DR. Thus, these patients should be co-managed with a retinal specialist. Also, anti-VEGF therapy has recently been shown as an effective treatment for proliferative DR.
As many DR patients also have cardiovascular disease, the statement further says that, despite previous reports, aspirin use does not increase the risk of retinal hemorrhage and, therefore, is fine for these patients to use.
Finally, working with the patient’s entire health care team to preserve vision in DR patients is recommended in the statement. Essentially, early detection and timely treatment may be 98% effective in preventing severe vision loss from DR, according to the Journal of the American Medical Association.
A NEW TOOL
The new ADA position statement serves as a tool to help our patients who have DR. Hopefully, it will improve quality interaction amongst the patient’s entire health care team and eye care providers in preventing the onset and progression of DM-related vision loss. OM




